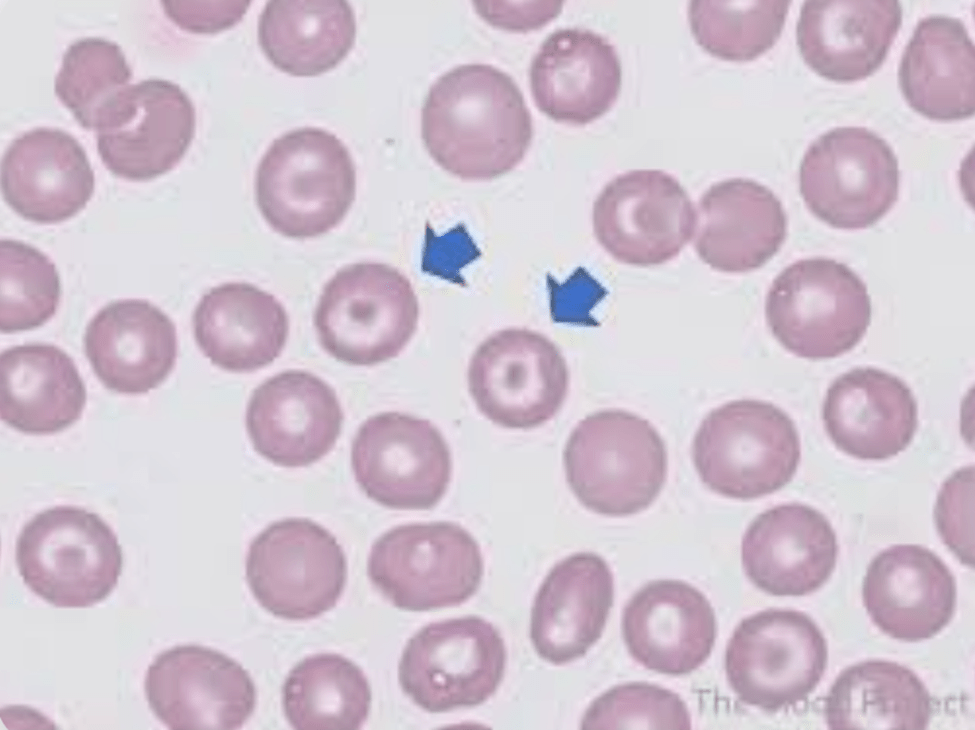

Which patient(s) do you need to ask about e-cigarette use?
All of them
What are the (four) general complications associated with cirrhosis? (Must get all four)
1) Portal HTN
2) Encephalopathy
3) Portal Vein Thrombosis
4) HCC
24y/o/F hgb 10, MCV 78 and plts 650. TIBC is elevated. Diagnosis?
Iron Deficiency Anemia
What is the classic murmur in AS?
Crescendo-decrescendo systolic ejection murmur best heard at the right upper sternal border, often radiating to the carotid arteries.
This 1998 Spielberg film follows Army Rangers landing at Omaha Beach and find a soldier in the middle of WWII?
What is Saving Private Ryan?
This DIY modification technique increases risk by heating oils directly on coils.
What is Dripping?
Which NSBB improves portal pressures through α-1 blockade and should be considered in both compensated and decompensated cirrhosis.
What is carvedilol.
A patient taking metformin for years developed macrocytic anemia and loss of vibratory sensation. Why?
What is B12 deficiency.
Name all three cardinal symptoms of AS?
1) Dyspnea
2) Angina
3) Syncope
This true-story film depicts SEAL Team rescue attempts from Somali pirates in 2009.
What is Captain Phillips?
What strategy for ventilation is used in EVALI cases with ARDS?
What are lung-protective measures (low tidal volumes, limited plateau pressures)?
First-line therapy for hepatic encephalopathy and how is it titrated?
What is Lactulose? Titrate to 2-3 BM's per day.
a 79 y/o/M has a CBC and symptoms concerning for MDS. What are the expected Bone Bx findings?
Hypercellular with dysplasia and <20% blasts.
Name two reasons you might get a TEE in a patient with moderate MR who is asymptomatic?
1) Decreased EF (<60%)
2) Evidence of remodeling (Eccentric LVH)
What real-world hero and medic was depicted in the 2016 film‘‘Hacksaw Ridge“ about a WWII Medal of Honor recipient?
Who is, Desmond Doss! 
These three factors MUST be present if considering outpatient management of a patient with EVALI?
Consider in patients with SpO2 >95%
Strong access to health care
Follow up in 24-48hrs
This clinical decision-making tool may be used to determine the futility of steroids in alcoholic hepatitis after the first 7 days of treatment.
What is the Lillie score.

A 23 y/o/F is undergoing a work-up for suspected thalassemia. List findings you may see on her peripheral smear? (Must name at least 3)
1) Microcytosis
2) Nucleated RBCs
3) Target Cells
4) Hypochromia
5) Anisopoikilocytosis (vary significantly in both size (anisocytosis) and shape (poikilocytosis))
46y/o/F with new Afib has an apical murmur and undergoes a TTE. What is the valvular dysfunction and likely etiology?

Rheumatic Mitral Stenosis.
This TV series aired from 1972 – 1983 and portrayed the members of the 4077th Mobile Army Surgical Hospital as they cared for the injured during the Korean War and used humor to escape from the horror and depression of the war.
What is M.A.S.H
This substance was identified by the CDC as the primary chemical of concern in the 2019 EVALI outbreak.
What is VEA (Synthetic Vitamin E/a-tocopherol acetate)
With liver stiffness measurement by transient elastography, which cutoff correlates with probable CSPH?
>15kPa
A liver stiffness measurement works by sending a vibration wave through the liver and measuring the speed at which the wave travels.

45 y/o/F presents with fatigue, gingival bleeding and recurrent infections 8 weeks after starting methimazole. She has pancytopenia, ARC is near zero and bone marrow bx shows marked hypocellularity. Name the most likely diagnosis and two other conditions that you must consider?
Most likely = Drug Induced Aplastic Anemia
Others: Acute Leukemia and MDS (would expect Hypercellularity and blasts)
Name all three severe AS criteria on echo?
What is:

This film is based on the first major U.S. battle in Vietnam, led by Lt. Gen. Hal Moore and 1st Cavalry Division (Airmobile).
What is We Were Soldiers?